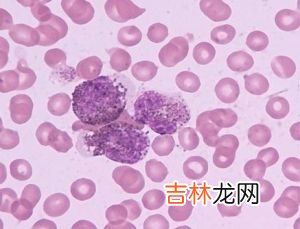

患者男,21岁,因全身间断发生红斑、脱屑伴瘙痒,偶尔发热2年,加重半个月,于1997年10月6日入院 。患者2年前,无明显诱因全身皮肤潮红,有少许渗液、结痂、脱屑,痒著伴低热,曾在某医院就诊考虑红皮病(湿疹引起)给予地塞米松5mg/d静脉滴注,治疗3d后减量,20d痊愈,皮肤颜色恢复正常 。10个月前,无明显诱因出现全身皮肤潮红、痒,外用“春蕾发乳”后加重,头部出现渗出、结痂伴发热38℃~39℃,结合病史无炎症性皮肤病及服药史,诊断红皮症(原因不明),给予地塞米松10mg/d静脉滴注4d,体温降至正常,肤色转暗红,浸润减轻,鳞屑减少;40d后地塞米松减量至3mg/d,维持2周改为泼尼松25mg/d,并逐渐减量,经45d减至泼尼松10mg/d,病情反跳,加用甲氨蝶呤,每周10mg加入5%葡萄糖液500ml中静脉滴注3周,增至每周15mg静脉滴注2周,效果不理想,全身皮肤仍然弥漫暗红、浸润、脱屑 。每月追踪观察并反复查肝肾功能、腹部b超均未发现异常 。半个月前,无明显诱因全身皮肤潮红加重,脱屑,痒明显,伴发热38℃~39.5℃入院 。既往身体健康 。
文章插图
【皮肤T细胞淋巴瘤性红皮病一例】 体检:体温38℃~39℃,血压14/10kpa(105/75mmhg),一般情况好 。面颈部、躯干、四肢可见弥漫暗红色浸润肥厚、肿胀,上覆细糠秕状鳞屑 。面颈部红斑浸润基础上可见绿豆大坚实丘疹 。头发及眉毛稀疏,指甲增厚、混浊有横嵴 。颈部、左腋下、腹股沟触及1cm×1cm~5cm×6cm大数个淋巴结,质硬如橡皮,光滑无压痛,活动性差 。肝脾不大 。实验室检查:血红蛋白133~150g/l,白细胞(11.7~23.0)×109/l,中性粒细胞0.46~0.75,淋巴细胞0.21~0.48,未见不典型淋巴细胞,s%26eacute;zary细胞阴性(1次),甲胎蛋白、癌胚抗原阴性,电解质、肝肾功能正常;b超未见异常 。骨髓象大致正常 。颈部皮损组织病理改变:棘层肥厚,皮突不规则向下延伸,无pautrier脓肿;真皮内可见异型肿瘤细胞呈苔藓样浸润,细胞及胞核多形性,胞浆透明,小血管增生明显,其周围亦有肿瘤细胞浸润,真皮浅层未见无浸润带 。左腹股沟淋巴结组织病理:大量的异型淋巴样细胞浸润,淋巴滤泡破坏,肿瘤细胞形态同真皮;上述两处皮损免疫组化lca(+)、cd20(-)、cd45(+++);皮损ck表达:表皮(+),肿瘤细胞团(-);溶菌酶肿瘤细胞团(-) 。最后诊断皮肤t细胞淋巴瘤性红皮病 。给予bacop方案,即平阳霉素、阿霉素、环磷酰胺、长春新碱、泼尼松,3个疗程后皮损大部分消退,淋巴结缩小至1cm×1cm 。讨论 本病经免疫组化确定为皮肤t细胞淋巴瘤,需与s%26eacute;zary综合征、成人t细胞白血病鉴别,前者好发于中老年人,红皮症伴有水肿与色素沉着,结合病理及反复多次在外周血内能找到较多的有特征的s%26eacute;zary细胞可以鉴别;后者伴有发热、贫血、肝脾肿大等全身症状,末梢血及骨髓象中可见幼稚白细胞可以鉴别 。本病提示皮肤病变是初发,淋巴结损害是继发 。恶性肿瘤和红皮病两者在发病时间上,多数患者红皮病比恶性肿瘤先发 。因此对原因不明的红皮病,浸润显著,其上出现丘疹、结节,瘙痒严重,一般治疗效果不理想,并进行性加重的皮肤损害,需提高警惕,详细询问病史,定期随访,全面检查,尤其是皮肤组织病理学方面的有关检查,寻找病因,争取治疗机会 。
经验总结扩展阅读
- 晚期皮肤梅毒伴心血管梅毒一例
- 益康唑醋酸曲安奈德霜治疗皮肤浅部真菌感染的床疗效观察
- 益康唑和曲安奈德霜治疗皮肤真菌病的疗效观察
- 16型人乳头瘤病毒E6/E7诱导角质形成细胞表达热休克蛋白70
- 中药白芨促进角质形成细胞的游走
- 中华皮肤科杂志引文分析
- 糠酸莫米松霜治疗特殊部位皮肤病
- 迟发性皮肤卟啉病合并丙型肝炎病毒感染一例
- 成纤维细胞与纤连蛋白粘附及其诱导的酪氨酸磷酸化蛋白
- 扁平苔藓中细胞凋亡相关基因bcl-2Fasbax的检测
